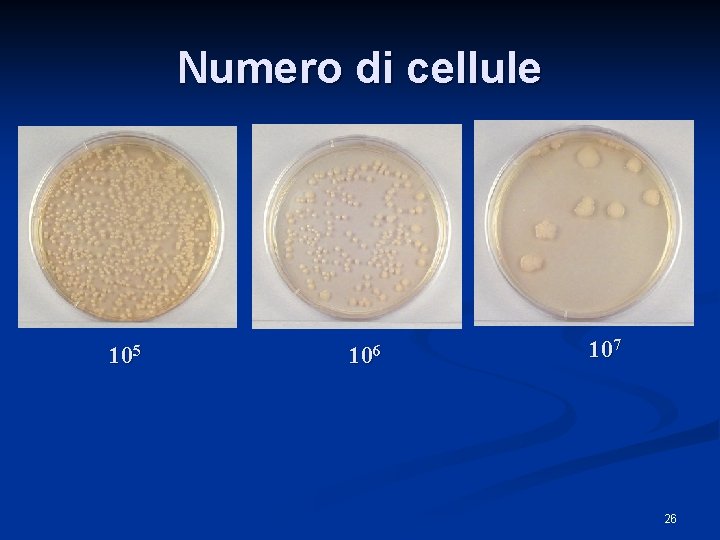
Numero di cellule 105 106 107 26
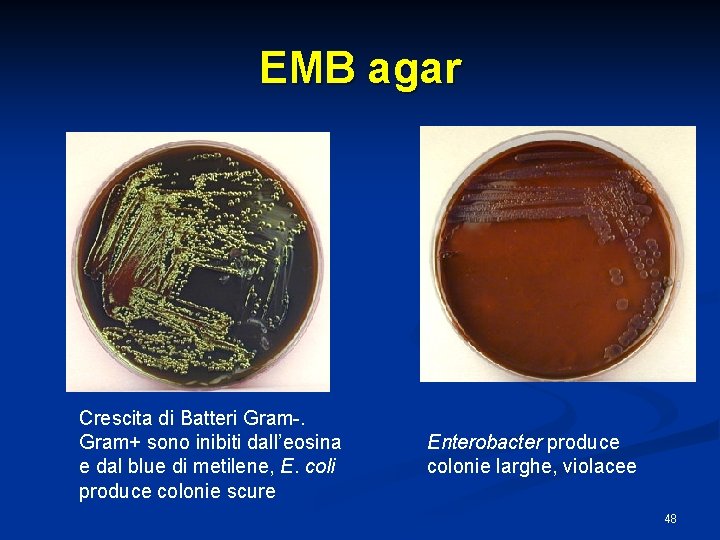
EMB agar Crescita di Batteri Gram-. Gram+ sono inibiti dall’eosina e dal blue di
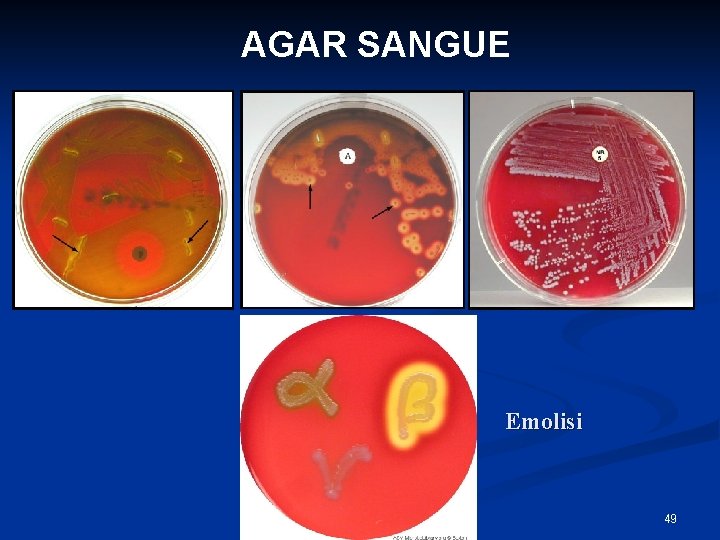
AGAR SANGUE Emolisi 49

Tecniche microbiologiche 1 MICROSCOPIO OTTICO 2 Microscopio ottico

Tecniche microbiologiche 1

MICROSCOPIO OTTICO 2

Microscopio ottico 3

Ingrandimento oculare X Ingrandimento obbiettivo = Ingrandimento totale 4

Ingrandimento n n n L’ingrandimento dell’oggetto da osservare è determinato dal prodotto del potere di ingrandimento dell’oculare (610 x) per il potere di ingrandimento dell’obbiettivo (10100 x) Gli obbiettivi anche in base all’ingrandimento sono definiti a secco o ad immersione L’ingrandimento dell’oggetto dovuto alle lenti dell’obbiettivo è un’immagine reale, ingrandita e rovesciata, viene ingrandita dall’oculare determinando una immagine virtuale diritta ed ingrandita 5

L’immagine oltre che ingrandita Deve essere: n Sufficientemente e convenientemente illuminata n Priva di aberrazioni cromatiche e di sfericità n Nitida permettendo la discriminazione di due punti dell’immagine vicinissimi (potere di risoluzione dell’obbiettivo) 6

Il potere di risoluzione (R) di un obbiettivo n n n n La capacità di distinguere chiaramente due punti vicinissimi tra loro è rappresentato da un numero che indica il diametro dell’oggetto più piccolo perfettamente distinguibile Più piccolo è il numero migliore risulta il potere risolvente Il potere di risoluzione è dato dalla seguente formula R=0. 61 λ/NA Λ lunghezza d’onda della luce NA è l’apertura numerica (n x sen α) n è l’indice di rifrazione del mezzo interposto tra obbiettivo e l’oggetto α è la metà dell’angolo di apertura dell’obbiettivo 7

Osservazione a secco 8

OBIETTIVO AD IMMERSIONE 9

Indice di rifrazione n n Negli obbiettivi a secco il mezzo interposto è l’aria l’indice di rifrazione è = 1, tali obbiettivi danno ingrandimenti non elevati con scarso potere di risoluzione e apertura numerica inferiore ad 1 Negli obbiettivi ad immersione il mezzo interposto è l’olio di cedro con indice di rifrazione tra 1, 51 -1, 53, danno ingrandimenti elevati (100 x) con apertura numerica superiore ad 1 10

Microscopio a contrasto di fase n n Permette di differenziare meglio le strutture interne dei microrganismi a fresco in base alla differente rifrazione delle strutture rispetto al protoplasma circostante È composto da un diaframma anulare che è formato da un anello cavo centrale attraverso il quale passano i raggi luminosi situato al di sotto del condensatore e da una lamina di fase costituita da materiale trasparente e provvista di un solco circolare meno spesso corrispondente all’anello cavo del diaframma situata dietro la lente frontale dell’obbiettivo con funzione ritardatrice 11

MICROSCOPIO A CONTRASTO DI FASE PIANO DELL’IMMAGINE OCULARE ANELLO DI FASE OBIETTIVO CAMPIONE CONDENSATORE LUCE 12

Osservazione diretta di preparati non colorati n n Preparazione in soluzione fisiologica: Materiali: Na. Cl 0, 85%, vetrini portaoggetto, paraffina Tecnica: stemperare una quantità di campione in una goccia di soluzione fisiologica. Osservazione Scopo: osservazione preliminare 13

Preparazione del vetrino per la colorazione Preparazione del materiale Distensione Essiccamento Fissazione 14

Fissazione n n n Al calore: si preserva la morfologia ma non le strutture intracellulari Fissazione chimica: protegge le strutture intracellulari e la morfologia di microrganismi più grossi e delicati Meccanismo: il fissante chimico penetra nella cellula e reagisce con i componenti cellulari (diventano insolubili ed immobili) Composizione: etanolo- acido aceticoformaldeide 15

Colorazione semplice n n Colorazione con blu di metilene Scopo: per l’osservazione dei batteri (forma, dimensione) 16

Colorazione di Gram 17

Colorazione di GRAM Colorazione differenziale n Cristal violetto e lugol si combinano a formare grosse molecole che precipitano sulla cellula n Alcool ed acetone dissolvono la membrana esterna il sottile strato di peptidoglicano è incapace di trattenere il colore n 18

Colorazione di Gram 19

Conta delle colonie 20

Assorbanza 21

Metodo per diluizione 22

Metodo per diluizione 23

Metodo per diluizione 24

Metodo per diluizione 25
Numero di cellule 105 106 107 26

Conta microbica utilizzando penna conta colonie Conta microbica utilizzando lente d’ingrandimento 27

CONTACOLONIE ELETTRONICO 28

SEMINA SU PIASTRA PER ISOLAMENTO COLONIE 29

PRELIEVO DA PIASTRA 30

Prelievo colonia 31

Tecnica per l’isolamento 32

Tecnica di isolamento 33

COLONIE MISTE 34

Colture pure e caratteri colturali: popolazioni microbiche naturali I microrganismi, quando crescono su un terreno di laboratorio, sono chiamati coltura. Colture miste Differenti specie microbiche cellule abitano varie parti del corpo (orale, intestinale, cutanea) madre. e dell’ambiente (aria, suolo, acqua). Colture pure Popolazione di derivate tutte da un’unica cellula 35

Coltivazione dei batteri Per studiare i microrganismi devono poter essere coltivati in laboratorio. Per questo scopo si devono conoscere quali sostanze nutritizie e quali condizioni fisiche essi richiedono. Queste informazioni hanno consentito di sviluppare numerosi terreni di coltura. 36

Terreni di coltura Selettivi inibiscono la crescita di un gruppo di microrganismi mentre permettono la crescita di altri n Differenziali contengono sostanze che permettono di evidenziare una determinata reazione chimica con cambiamento di colore n Arricchiti contengono sostanze (sangue, siero, emoglobina ) che permettono la crescita di alcuni microrganismi n 37

Preparazione dei terreni colturali 1. Dissoluzione degli ingredienti in volume di H 2 O. 2. Determinazione correzione. 3. Distribuzione in contenitori idonei. 4. Sterilizzazione. del p. H ed eventuale 38

TERRENO A BECCO DI CLARINO 39

TERRENO LIQUIDO 40

Terreni batteriologici semisolido (+Agar 0, 5%) Solido (+Agar 2%) 41

Terreni solidificabili n Possibilità di aggiungere sostanze termolabili § Mezzi per il conteggio dei batteri. § Mezzi per la caratterizzazione batterica § Terreni di mantenimento. 42

Agar Sostanza polisaccaridica (estere solforico di una molecola lineare di galattano) di alghe rosse marine della famiglia delle Geliciaee. La solidificazione varia a seconda del tipo alga da cui deriva. Non presenta alcuna caratteristica nutritiva per i microbi. Componenti fisiche: § punto di fusione 85°C; § stato di soprafusione fino a 42°C; 43

Terreni solidi: colonia n Capacità di una singola cellula di formare una colonia n Masse visibili di cellule formate dalle successive divisioni di una o piu’ cellule n Numero di cellule 107 -108 44

Colonie batteriche 45

Valutazione delle colonie a) b) c) d) e) f) g) h) osservazione del terreno attorno alle colonie (attività metaboliche) dimensioni (diametro) margine o bordo. rilievo colore superficie trasparenza consistenza. 46

Valutazione delle colonie S. aureus: convessa, bordo regolare, diametro 2 -3 mm, cremosa, giallastra, beta emolisi E. coli: cupoliforme, opaca, grigia, 47
EMB agar Crescita di Batteri Gram-. Gram+ sono inibiti dall’eosina e dal blue di metilene, E. coli produce colonie scure Enterobacter produce colonie larghe, violacee 48
AGAR SANGUE Emolisi 49

MANNITOL SALT AGAR 50

SENSIBILITA’ AGLI AGENTI ANTIMICROBICI Disk Diffusion Test Determination of MIC Str Tet 8 4 2 1 0 Tetracycline ( g/ml) MIC = 2 g/ml Ery Chl Amp 51

Definizioni Concentrazione Minima Inibente (MIC) E’ la concentrazione più bassa di a. a. in grado di inibire la crescita microbica Concentrazione Minima Battericida (MBC) La più bassa concentrazione di a. a. che determina la morte del 99, 9% dei batteri presenti 52

Determinazione delle sensibilita’ agli agenti antimicrobici mediante prova per diluizione in terreno liquido. Calcolo della Minima Concentrazione Inibente (MIC) e della Minima Concentrazione Battericida (MBC) 53

Determinazione delle sensibilita’ agli agenti antimicrobici mediante prova per diluizione in terreno liquido. Calcolo della Minima Concentrazione Inibente (MIC) e della Minima Concentrazione Battericida (MBC) 54

ANTIBIOGRAMMA 55

METODO PER DIFFUSIONE (ANTIBIOGRAMMA) 56

ANTIBIOGRAMMA 57

58

59

RILEVAZIONE BASATA SU PARTICOLARI PROPRIETA’ DEL VIRUS mediante EMOAGGLUTINAZIONE Si basa sulla capacità della proteina emoagglutinina di legarsi ai recettori presenti sugli eritrociti di alcune specie animali (emazie di pollo) o su eritrociti umani 0 Rh+. La reazione di emoagglutinazione causa una aggregazione (formazione di un reticolo) delle emazie visibile ad occhio nudo. Usato per la titolazione del virus influenzale e del virus parainfluenzale 60

Emoagglutinazione Diluizioni seriali 1/2 del campione in multiwell da 96 pozzetti. Aggiunta di uguale volume di eritrociti diluiti in tampone allo 0. 5%. Incubazione a Temperatura ambiente per circa 1 ora. Formazione del reticolo dove è presente il virus. Formazione di un precipitato bottone rosso in assenza di virus. Titolo emoagglutinante è rappresentato dall’ultima diluizione che da’ Emoagglutinazione completa 61

RILEVAZIONE BASATA SU PARTICOLARI PROPRIETA’ DEL VIRUS mediante EMOADSORBIMENTO Principio identico all’emoagglutinazione ma tecnica eseguita su colture cellulari. Le cellule infettate esprimono sulla membrana plasmatica l’emoagglutinina virale. Vengono aggiunti eritrociti alla coltura cellulare e si attende la formazione di rosette costituite da una singola cellula infetta circondata da eritrociti. 62

RILEVAZIONE DELL’INFETTIVITA’ mediante SAGGI BIOLOGICI Il campione viene posto su colture cellulari uova embrionate di pollo animali da esperimento La moltiplicazione virale può essere valutata tramite: Visualizzazione effetto citopatico indotto dal virus Metodiche descritte in precedenza 63

Colture cellulari Colture primarie cellule ottenute da espianto di tessuto prelevato da un organismo vivente. Durata 1 -2 replicazioni cellulari. Colture continue cellule ottenute da colture primarie trasformate. Possono essere propagate indefinitamente. 64

Cappa sterile a flusso laminare verticale Terreno di coltura Ricco di sali, aminoacidi, vitamine Fiasca sterile Incubatore a CO 2 Siero fetale bovino Ricco di fattori di crescita 65

RILEVAZIONE DELL’INFETTIVITA’ mediante VISUALIZZAZIONE EFFETTO CITOPATICO INDOTTO DAL VIRUS Valutazione del monostrato cellulare infettato al microscopio ottico a contrasto di fase Cellule MDCK Cellule VERO Controllo Infettate con virus influenzale Controllo Infettate con virus erpetico 66

RILEVAZIONE DELL’INFETTIVITA’ mediante METODO DELLE PLACCHE Diluizioni seriali 1/10 del campione su monostrati confluenti di cellule sensibili all’infezione. Dopo l’infezione aggiunta di uno strato di agar molle e piastre lasciate in incubatore da 24 a 72 ore permettere la formazione delle placche (zone circoscritte di effetto citopatico). Colorazione con coloranti vitali (es. cristalvioletto). PLACCA teoricamente la progenie virale contenuta in una placca è la progenie di un singolo clone. Usato per la titolazione di diversi virus fra cui virus influenzale, virus erpetico, rhinovirus, coronavirus TITOLAZIONE n° di placche/ml = p. f. u. /ml 67
- Slides: 67